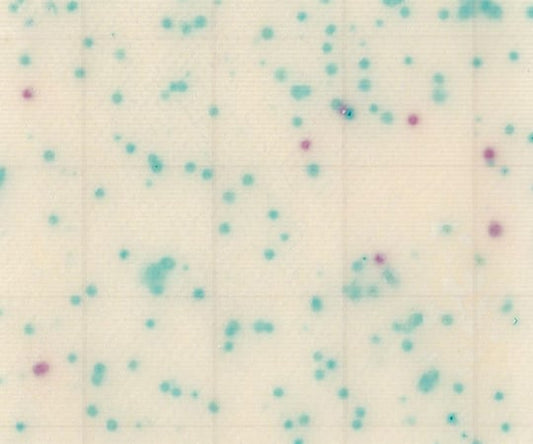
MC-Media Pad EC 大腸菌・大腸菌群用 (100枚)　SK04B25 1箱(25枚×4袋入)

コレクション: 簡易培地・フィルム培地
-
コンパクトドライ (サルモネラ検出用/4枚×60袋) 06733 1箱(4枚×60袋入)
通常価格 ¥26,400通常価格単価 / あたり -
コンパクトドライ (大腸菌群数測定用/4枚×60袋) 06745 1箱(4枚×60袋入)
通常価格 ¥26,400通常価格単価 / あたり -
コンパクトドライ (一般生菌数測定用/4枚×60袋) 06741 1箱(4枚×60袋入)
通常価格 ¥26,400通常価格単価 / あたり -
コンパクトドライ (酵母|カビ測定用/4枚×60袋) 06747 1箱(4枚×60袋入)
通常価格 ¥44,880通常価格単価 / あたり -
コンパクトドライ (腸炎ビブリオ測定用/4枚×60袋) 06749 1箱(4枚×60袋入)
通常価格 ¥26,400通常価格単価 / あたり -
コンパクトドライ (セレウス菌検出用/4枚×60袋) 06534 1箱(4枚×60袋入)
通常価格 ¥42,240通常価格単価 / あたり -
MC-Media Pad ACplus(R-AC) 一般生菌用迅速/一般生菌用 兼用 (100枚) SK01B25 1箱(25枚×4袋入)
通常価格 ¥11,000通常価格単価 / あたり -
MC-Media Pad ACplus(R-AC) 一般生菌用迅速/一般生菌用 兼用 (1000枚) SK01A25 1ケース(100枚×10箱入)
通常価格 ¥88,000通常価格単価 / あたり -
バイオチェッカー 1箱(10本入) 希釈キット 1箱(10本入)
通常価格 ¥5,500通常価格単価 / あたり -
MC-Media Pad 一般生菌用 (100枚) SK99B25 1箱(25枚×4袋入)
通常価格 ¥11,000通常価格単価 / あたり -
MC-Media Pad サルモネラ用 (100枚) SK06B25 1箱(25枚×4袋入)
通常価格 ¥22,000通常価格単価 / あたり -
MC-Media Pad YM 真菌(カビ・酵母)用(100枚) SK05B25 1箱(25枚×4袋入)
通常価格 ¥19,800通常価格単価 / あたり -
MC-Media Pad SA 黄色ブドウ球菌用 (100枚) SK03B25 1箱(25枚×4袋入)
通常価格 ¥16,500通常価格単価 / あたり -
MC-Media Pad CC 大腸菌群用 (100枚) SK02B25 1箱(25枚×4袋入)
通常価格 ¥11,000通常価格単価 / あたり -
MC-Media Pad EC 大腸菌・大腸菌群用 (100枚) SK04B25 1箱(25枚×4袋入)
通常価格 ¥16,500通常価格単価 / あたり -
MC-Media Pad 一般生菌用 (1000枚) SK99A25 1ケース(100枚×10箱入)
通常価格 ¥88,000通常価格単価 / あたり